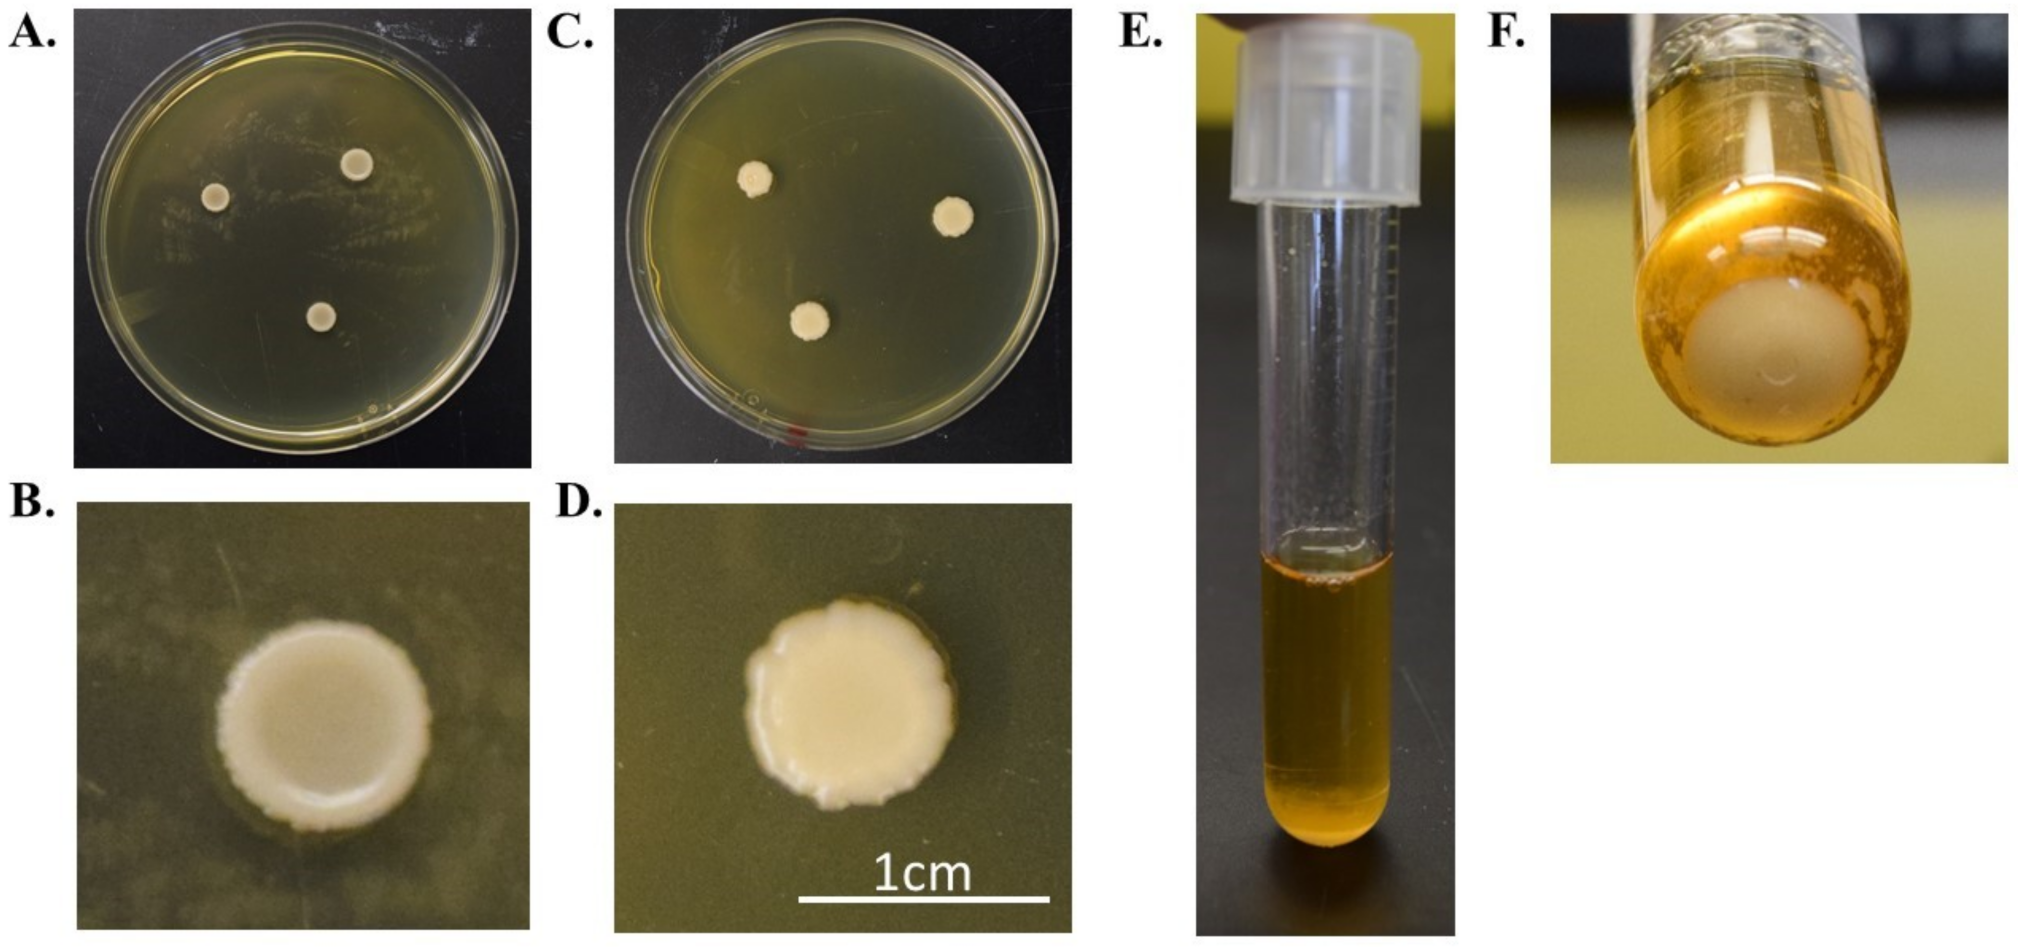
Jof 07 00146 g001

Characterization of Kazachstania slooffiae, a Proposed Commensal in the Porcine Gut
Abstract
1. Introduction
2. Materials and Methods
3. Results
4. Discussion
Author Contributions
Funding
Institutional Review Board Statement
Informed Consent Statement
Data Availability Statement
Acknowledgments
Conflicts of Interest
References
- Campbell, J.M.; Crenshaw, J.D.; Polo, J. The biological stress of early weaned piglets. J. Anim. Sci. Biotechnol. 2013, 4, 19. [Google Scholar] [CrossRef]
- Guevarra, R.B.; Hong, S.H.; Cho, J.H.; Kim, B.R.; Shin, J.; Lee, J.H.; Kang, B.N.; Kim, Y.H.; Wattanaphansak, S.; Isaacson, R.E.; et al. The dynamics of the piglet gut microbiome during the weaning transition in association with health and nutrition. J. Anim. Sci. Biotechnol. 2018, 9, 54. [Google Scholar] [CrossRef] [PubMed]
- Guevarra, R.B.; Lee, J.H.; Lee, S.H.; Seok, M.J.; Kim, D.W.; Kang, B.N.; Johnson, T.J.; Isaacson, R.E.; Kim, H.B. Piglet gut microbial shifts early in life: Causes and effects. J. Anim. Sci. Biotechnol. 2019, 10, 1. [Google Scholar] [CrossRef]
- Huffnagle, G.B.; Noverr, M.C. The emerging world of the fungal microbiome. Trends Microbiol. 2013, 21, 334–341. [Google Scholar] [CrossRef] [PubMed]
- Ott, S.J.; Kuhbacher, T.; Musfeldt, M.; Rosenstiel, P.; Hellmig, S.; Rehman, A.; Drews, O.; Weichert, W.; Timmis, K.N.; Schreiber, S. Fungi and inflammatory bowel diseases: Alterations of composition and diversity. Scand. J. Gastroenterol. 2008, 43, 831–841. [Google Scholar] [CrossRef] [PubMed]
- Iliev, I.D.; Funari, V.A.; Taylor, K.D.; Nguyen, Q.; Reyes, C.N.; Strom, S.P.; Brown, J.; Becker, C.A.; Fleshner, P.R.; Dubinsky, M.; et al. Interactions between commensal fungi and the C-type lectin receptor Dectin-1 influence colitis. Science 2012, 336, 1314–1317. [Google Scholar] [CrossRef] [PubMed]
- Mason, K.L.; Erb Downward, J.R.; Falkowski, N.R.; Young, V.B.; Kao, J.Y.; Huffnagle, G.B. Interplay between the gastric bacterial microbiota and Candida albicans during postantibiotic recolonization and gastritis. Infect. Immun. 2012, 80, 150–158. [Google Scholar] [CrossRef]
- Erb Downward, J.R.; Falkowski, N.R.; Mason, K.L.; Muraglia, R.; Huffnagle, G.B. Modulation of post-antibiotic bacterial community reassembly and host response by Candida albicans. Sci. Rep. 2013, 3, 2191. [Google Scholar] [CrossRef]
- Li, Q.; Wang, C.; Tang, C.; He, Q.; Li, N.; Li, J. Dysbiosis of gut fungal microbiota is associated with mucosal inflammation in Crohn’s disease. J. Clin. Gastroenterol. 2014, 48, 513–523. [Google Scholar] [CrossRef] [PubMed]
- Liu, Y.; Zheng, Z.; Yu, L.; Wu, S.; Sun, L.; Wu, S.; Xu, Q.; Cai, S.; Qin, N.; Bao, W. Examination of the temporal and spatial dynamics of the gut microbiome in newborn piglets reveals distinct microbial communities in six intestinal segments. Sci. Rep. 2019, 9, 3453. [Google Scholar] [CrossRef]
- Frey-Klett, P.; Burlinson, P.; Deveau, A.; Barret, M.; Tarkka, M.; Sarniguet, A. Bacterial-fungal interactions: Hyphens between agricultural, clinical, environmental, and food microbiologists. Microbiol. Mol. Biol. Rev. 2011, 75, 583–609. [Google Scholar] [CrossRef] [PubMed]
- Suhr, M.J.; Hallen-Adams, H.E. The human gut mycobiome: Pitfalls and potentials—A mycologist’s perspective. Mycologia 2015, 107, 1057–1073. [Google Scholar] [CrossRef]
- Mukherjee, P.K.; Sendid, B.; Hoarau, G.; Colombel, J.F.; Poulain, D.; Ghannoum, M.A. Mycobiota in gastrointestinal diseases. Nat. Rev. Gastroenterol Hepatol. 2015, 12, 77–87. [Google Scholar] [CrossRef]
- Kureljusic, B.; Weissenbacher-Lang, C.; Nedorost, N.; Stixenberger, D.; Weissenbock, H. Association between Pneumocystis spp. and co-infections with Bordetella bronchiseptica, Mycoplasma hyopneumoniae and Pasteurella multocida in Austrian pigs with pneumonia. Vet. J. 2016, 207, 177–179. [Google Scholar] [CrossRef]
- Weissenbacher-Lang, C.; Kureljusic, B.; Nedorost, N.; Matula, B.; Schiessl, W.; Stixenberger, D.; Weissenbock, H. Retrospective Analysis of Bacterial and Viral Co-Infections in Pneumocystis spp. Positive Lung Samples of Austrian Pigs with Pneumonia. PLoS ONE 2016, 11, e0158479. [Google Scholar] [CrossRef] [PubMed][Green Version]
- Iliev, I.D.; Leonardi, I. Fungal dysbiosis: Immunity and interactions at mucosal barriers. Nat. Rev. Immunol. 2017, 17, 635–646. [Google Scholar] [CrossRef]
- Limon, J.J.; Skalski, J.H.; Underhill, D.M. Commensal Fungi in Health and Disease. Cell Host Microbe. 2017, 22, 156–165. [Google Scholar] [CrossRef]
- Richard, M.L.; Sokol, H. The gut mycobiota: Insights into analysis, environmental interactions and role in gastrointestinal diseases. Nat. Rev. Gastroenterol. Hepatol. 2019, 16, 331–345. [Google Scholar] [CrossRef] [PubMed]
- Arfken, A.M.; Frey, J.F.; Ramsay, T.G.; Summers, K.L. Yeasts of Burden: Exploring the Mycobiome-Bacteriome of the Piglet GI Tract. Front. Microbiol. 2019, 10, 2286. [Google Scholar] [CrossRef]
- Arfken, A.M.; Frey, J.F.; Summers, K.L. Temporal Dynamics of the Gut Bacteriome and Mycobiome in the Weanling Pig. Microorganisms 2020, 8, 868. [Google Scholar] [CrossRef]
- Summers, K.L.; Frey, J.F.; Ramsay, T.G.; Arfken, A.M. The piglet mycobiome during the weaning transition: A pilot study. J. Anim. Sci. 2019, 97, 2889–2900. [Google Scholar] [CrossRef] [PubMed]
- Urubschurov, V.; Busing, K.; Freyer, G.; Herlemann, D.P.; Souffrant, W.B.; Zeyner, A. New insights into the role of the porcine intestinal yeast, Kazachstania slooffiae, in intestinal environment of weaned piglets. FEMS Microbiol. Ecol. 2017, 93. [Google Scholar] [CrossRef]
- Urubschurov, V.; Busing, K.; Janczyk, P.; Souffrant, W.B.; Zeyner, A. Development and Evaluation of qPCR Assay for Quantitation of Kazachstania slooffiae and Total Yeasts Occurring in the Porcine Gut. Curr. Microbiol. 2015, 71, 373–381. [Google Scholar] [CrossRef] [PubMed]
- Urubschurov, V.; Busing, K.; Souffrant, W.B.; Schauer, N.; Zeyner, A. Porcine intestinal yeast species, Kazachstania slooffiae, a new potential protein source with favourable amino acid composition for animals. J. Anim. Physiol. Anim. Nutr. (Berl) 2018, 102, e892–e901. [Google Scholar] [CrossRef]
- Urubschurov, V.; Janczyk, P.; Pieper, R.; Souffrant, W.B. Biological diversity of yeasts in the gastrointestinal tract of weaned piglets kept under different farm conditions. FEMS Yeast Res. 2008, 8, 1349–1356. [Google Scholar] [CrossRef][Green Version]
- Urubschurov, V.; Janczyk, P.; Souffrant, W.B.; Freyer, G.; Zeyner, A. Establishment of intestinal microbiota with focus on yeasts of unweaned and weaned piglets kept under different farm conditions. FEMS Microbiol. Ecol. 2011, 77, 493–502. [Google Scholar] [CrossRef]
- Kurtzman, C.P.; Robnett, C.J.; Ward, J.M.; Brayton, C.; Gorelick, P.; Walsh, T.J. Multigene phylogenetic analysis of pathogenic candida species in the Kazachstania (Arxiozyma) telluris complex and description of their ascosporic states as Kazachstania bovina sp. nov., K. heterogenica sp. nov., K. pintolopesii sp. nov., and K. slooffiae sp. nov. J. Clin. Microbiol. 2005, 43, 101–111. [Google Scholar] [PubMed]
- White, T.J.; Burns, T.; Lee, S.; Taylor, J. Amplification and sequencing of fungal ribosomal RNA genes for phylogenetics. In PCR Protocols: A Guide to Methods and Applications; Innis, M.A., Gelfand, D.H., Sninsky, J.J., White, T.J., Eds.; Academic Press: San Diego, CA, USA, 1990; pp. 315–322. [Google Scholar]
- Chin, C.S.; Peluso, P.; Sedlazeck, F.J.; Nattestad, M.; Concepcion, G.T.; Clum, A.; Dunn, C.; O’Malley, R.; Figueroa-Balderas, R.; Morales-Cruz, A.; et al. Phased diploid genome assembly with single-molecule real-time sequencing. Nat. Methods 2016, 13, 1050–1054. [Google Scholar] [CrossRef]
- Usyk, M.; Zolnik, C.P.; Patel, H.; Levi, M.H.; Burk, R.D. Novel ITS1 Fungal Primers for Characterization of the Mycobiome. mSphere 2017, 2. [Google Scholar] [CrossRef]
- Vainio, E.J.; Hantulo, J. Direct analysis of wood-inhabiting fungi using denaturing gradient gel electrophoresis of amplified ribosomal DNA. Mycol. Res. 2000, 104, 927–936. [Google Scholar] [CrossRef]
- Bengtsson-Palme, J.; Ryberg, M.; Hartmann, M.; Branco, S.; Wang, Z.; Godhe, A.; De Wit, P.; Sanchez-Garcia, M.; Ebersberger, I.; de Sousa, F.; et al. Improved software detection and extraction of ITS1 and ITS2 from ribosomal ITS sequences of fungi and other eukaryotes for analysis of environmental sequencing data. Methods Ecol. Evol. 2013. [Google Scholar] [CrossRef]
- O’Leary, N.A.; Wright, M.W.; Brister, J.R.; Ciufo, S.; Haddad, D.; McVeigh, R.; Rajput, B.; Robbertse, B.; Smith-White, B.; Ako-Adjei, D.; et al. Reference sequence (RefSeq) database at NCBI: Current status, taxonomic expansion, and functional annotation. Nucleic Acids Res. 2016, 44, D733–D745. [Google Scholar] [CrossRef]
- Edgar, R.C. MUSCLE: Multiple sequence alignment with high accuracy and high throughput. Nucleic Acids Res. 2004, 32, 1792–1797. [Google Scholar] [CrossRef] [PubMed]
- Tamura, K.; Nei, M. Estimation of the number of nucleotide substitutions in the control region of mitochondrial DNA in humans and chimpanzees. Mol. Biol. Evol. 1993, 10, 512–526. [Google Scholar]
- Kumar, S.; Stecher, G.; Li, M.; Knyaz, C.; Tamura, K. MEGA X: Molecular Evolutionary Genetics Analysis across Computing Platforms. Mol. Biol. Evol. 2018, 35, 1547–1549. [Google Scholar] [CrossRef] [PubMed]
- Dassanayake, R.P.; Falkenberg, S.M.; Stasko, J.A.; Shircliff, A.L.; Lippolis, J.D.; Briggs, R.E. Identification of a reliable fixative solution to preserve the complex architecture of bacterial biofilms for scanning electron microscopy evaluation. PLoS ONE 2020, 15, e0233973. [Google Scholar] [CrossRef] [PubMed]
- Haney, E.F.; Mansour, S.C.; Hilchie, A.L.; de la Fuente-Nunez, C.; Hancock, R.E. High throughput screening methods for assessing antibiofilm and immunomodulatory activities of synthetic peptides. Peptides 2015, 71, 276–285. [Google Scholar] [CrossRef] [PubMed]
- Chen, L.; Noorbakhsh, J.; Adams, R.M.; Samaniego-Evans, J.; Agollah, G.; Nevozhay, D.; Kuzdzal-Fick, J.; Mehta, P.; Balazsi, G. Two-dimensionality of yeast colony expansion accompanied by pattern formation. Plos Comput. Biol. 2014, 10, e1003979. [Google Scholar] [CrossRef] [PubMed]
- Neiman, A.M. Ascospore formation in the yeast Saccharomyces cerevisiae. Microbiol Mol. Biol Rev. 2005, 69, 565–584. [Google Scholar] [CrossRef]
- Imanishi, Y.; Ueda-Nishimura, K.; Mikata, K. Two new species of Kazachstania that form ascospores connected by a belt-like intersporal body: Kazachstania zonata and Kazachstania gamospora. FEMS Yeast Res. 2007, 7, 330–338. [Google Scholar] [CrossRef][Green Version]
- Tran, N.T.; Miles, A.K.; Smith, M.W.; Dietzgen, R.G.; Drenth, A. Pathogenicity of Phyllosticta citricarpa Ascospores on Citrus spp. Plant. Dis. 2018, 102, 1386–1393. [Google Scholar] [CrossRef]
- Njambere, E.N.; Chen, W.; Frate, C.; Temple, S.R. Ascospore dimorphism-associated mating types of Sclerotinia trifoliorum equally capable of inducing mycelial infection on chickpea plants. Australas. Plant. Pathol. 2011, 40, 648–655. [Google Scholar] [CrossRef]
- Trail, F. Fungal cannons: Explosive spore discharge in the Ascomycota. Fems Microbiol Lett 2007, 276, 12–18. [Google Scholar] [CrossRef] [PubMed]
- Coluccio, A.E.; Rodriguez, R.K.; Kernan, M.J.; Neiman, A.M. The yeast spore wall enables spores to survive passage through the digestive tract of Drosophila. PLoS ONE 2008, 3, e2873. [Google Scholar] [CrossRef]
- Wilcks, A.; Hansen, B.M.; Hendriksen, N.B.; Licht, T.R. Fate and effect of ingested Bacillus cereus spores and vegetative cells in the intestinal tract of human-flora-associated rats. FEMS Immunol. Med. Microbiol. 2006, 46, 70–77. [Google Scholar] [CrossRef]
- Neville, B.A.; d’Enfert, C.; Bougnoux, M.E. Candida albicans commensalism in the gastrointestinal tract. FEMS Yeast Res. 2015, 15. [Google Scholar]
- Calderone, R.A.; Fonzi, W.A. Virulence factors of Candida albicans. Trends Microbiol. 2001, 9, 327–335. [Google Scholar] [CrossRef]
- Mayer, F.L.; Wilson, D.; Hube, B. Candida albicans pathogenicity mechanisms. Virulence 2013, 4, 119–128. [Google Scholar] [CrossRef]
- Summers, K.L.; Arfken, A.M. The Gut Mycobiome and Animal Health; Springer: Berlin, Germany, 2021. [Google Scholar]
- Lofgren, L.A.; Uehling, J.K.; Branco, S.; Bruns, T.D.; Martin, F.; Kennedy, P.G. Genome-based estimates of fungal rDNA copy number variation across phylogenetic scales and ecological lifestyles. Mol. Ecol. 2019, 28, 721–730. [Google Scholar] [CrossRef] [PubMed]
- Lavrinienko, A.; Jernfors, T.; Koskimaki, J.J.; Pirttila, A.M.; Watts, P.C. Does Intraspecific Variation in rDNA Copy Number Affect Analysis of Microbial Communities? Trends Microbiol. 2021, 29, 19–27. [Google Scholar] [CrossRef]
- Todd, R.T.; Forche, A.; Selmecki, A. Ploidy Variation in Fungi: Polyploidy, Aneuploidy, and Genome Evolution. Microbiol. Spectr. 2017, 5. [Google Scholar]
- Galagan, J.E.; Henn, M.R.; Ma, L.J.; Cuomo, C.A.; Birren, B. Genomics of the fungal kingdom: Insights into eukaryotic biology. Genome Res. 2005, 15, 1620–1631. [Google Scholar] [CrossRef]
- Wenger, A.M.; Peluso, P.; Rowell, W.J.; Chang, P.C.; Hall, R.J.; Concepcion, G.T.; Ebler, J.; Fungtammasan, A.; Kolesnikov, A.; Olson, N.D.; et al. Accurate circular consensus long-read sequencing improves variant detection and assembly of a human genome. Nat. Biotechnol. 2019, 37, 1155–1162. [Google Scholar] [CrossRef]
- Jeffery-Smith, A.; Taori, S.K.; Schelenz, S.; Jeffery, K.; Johnson, E.M.; Borman, A.; Candida auris Incident Management Team; Manuel, R.; Brown, C.S. Candida auris: A Review of the Literature. Clin. Microbiol. Rev. 2018, 31. [Google Scholar] [CrossRef] [PubMed]
- Costa-de-Oliveira, S.; Rodrigues, A.G. Candida albicans Antifungal Resistance and Tolerance in Bloodstream Infections: The Triad Yeast-Host-Antifungal. Microorganisms 2020, 8, 154. [Google Scholar] [CrossRef]
- Lockhart, S.R.; Berkow, E.L.; Chow, N.; Welsh, R.M. Candida auris for the clinical microbiology laboratory: Not your grandfather’s Candida species. Clin. Microbiol. Newsl. 2017, 39, 99–103. [Google Scholar] [CrossRef] [PubMed]
- Borman, A.M.; Muller, J.; Walsh-Quantick, J.; Szekely, A.; Patterson, Z.; Palmer, M.D.; Fraser, M.; Johnson, E.M. Fluconazole Resistance in Isolates of Uncommon Pathogenic Yeast Species from the United Kingdom. Antimicrob. Agents Chemother. 2019, 63. [Google Scholar] [CrossRef] [PubMed]
- Tan, Y.; Leonhard, M.; Moser, D.; Schneider-Stickler, B. Inhibition activity of Lactobacilli supernatant against fungal-bacterial multispecies biofilms on silicone. Microb. Pathog. 2017, 113, 197–201. [Google Scholar] [CrossRef]
- Maslennikova, I.L.; Kuznetsova, M.V.; Nekrasova, I.V.; Shirshev, S.V. Effect of bacterial components of mixed culture supernatants of planktonic and biofilm Pseudomonas aeruginosa with commensal Escherichia coli on the neutrophil response in vitro. Pathog. Dis. 2017, 75. [Google Scholar] [CrossRef] [PubMed]
- Frickmann, H.; Klenk, C.; Warnke, P.; Redanz, S.; Podbielski, A. Influence of Probiotic Culture Supernatants on In Vitro Biofilm Formation of Staphylococci. Eur. J. Microbiol. Immunol. (Bp) 2018, 8, 119–127. [Google Scholar] [CrossRef]
- Tarkka, M.T.; Sarniguet, A.; Frey-Klett, P. Inter-kingdom encounters: Recent advances in molecular bacterium-fungus interactions. Curr. Genet. 2009, 55, 233–243. [Google Scholar] [CrossRef] [PubMed]
- Valle, J.; Da Re, S.; Henry, N.; Fontaine, T.; Balestrino, D.; Latour-Lambert, P.; Ghigo, J.M. Broad-spectrum biofilm inhibition by a secreted bacterial polysaccharide. Proc. Natl. Acad. Sci. USA 2006, 103, 12558–12563. [Google Scholar] [CrossRef] [PubMed]
- Charalampopoulos, D.; Pandiella, S.S.; Webb, C. Growth studies of potentially probiotic lactic acid bacteria in cereal-based substrates. J. Appl. Microbiol. 2002, 92, 851–859. [Google Scholar] [CrossRef] [PubMed]

| Primer Target | Primer Name | Primer Sequence (5′ -> 3′) | Citation |
|---|---|---|---|
| ITS-1 Forward | ITS1 | CTTGGTCATTTAGAGGAAGTAA | [30] |
| ITS-1 Reverse | ITS2 | GCTGCGTTCTTCATCGATGC | [30] |
| ITS-2 Forward | ITS3 | GCATCGATGAAGAACGCAGC | [28] |
| ITS-2 Reverse | ITS4 | TCCTCCGCTTATTGATATGC | [28] |
| 18S Forward | FF290F | CGATAACGAACGAGACCT | [31] |
| 18S Reverse | FR-1R | ANCCATTCAATCGGTANT | [31] |
| Antimicrobial | Susceptible [Y/N] | Antimicrobial Concentration | Drug class |
|---|---|---|---|
| Cefoperazone | N | 100 mg/mL | 3rd generation cephalosporin |
| Ampicillin | N | 100 mg/mL | Beta lactam (penicillin) |
| Caspofungin | Y | 0.094 ug/mL | Echinocandins |
| Itraconazole | Y | 0.25 ug/mL | Azoles |
| Voriconazole | Y | 0.023 ug/mL | Azoles |
| Fluconazole | Y | 20 ug/mL | Azoles |
| Amphotericin B | Y | 250 mg/mL | Polyenes |
| Flucytosine | Y | 1.0 ug/mL | Pyrimidine analogue |
Publisher’s Note: MDPI stays neutral with regard to jurisdictional claims in published maps and institutional affiliations. |
© 2021 by the authors. Licensee MDPI, Basel, Switzerland. This article is an open access article distributed under the terms and conditions of the Creative Commons Attribution (CC BY) license (http://creativecommons.org/licenses/by/4.0/).
Share and Cite
Summers, K.L.; Foster Frey, J.; Arfken, A.M. Characterization of Kazachstania slooffiae, a Proposed Commensal in the Porcine Gut. J. Fungi 2021, 7, 146. https://doi.org/10.3390/jof7020146
Summers KL, Foster Frey J, Arfken AM. Characterization of Kazachstania slooffiae, a Proposed Commensal in the Porcine Gut. Journal of Fungi. 2021; 7(2):146. https://doi.org/10.3390/jof7020146
Chicago/Turabian StyleSummers, Katie Lynn, Juli Foster Frey, and Ann M. Arfken. 2021. "Characterization of Kazachstania slooffiae, a Proposed Commensal in the Porcine Gut" Journal of Fungi 7, no. 2: 146. https://doi.org/10.3390/jof7020146
APA StyleSummers, K. L., Foster Frey, J., & Arfken, A. M. (2021). Characterization of Kazachstania slooffiae, a Proposed Commensal in the Porcine Gut. Journal of Fungi, 7(2), 146. https://doi.org/10.3390/jof7020146

